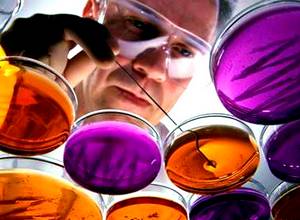

16 августа 2017
Любые отклонения в анализах, обнаруженные на этапе планирования или в процессе беременности, способны лишить будущую мать покоя и сна в тревоге за малыша. А медицинское сообщество продолжает рассказывать об опасных и особо опасных микроорганизмах. К таким «популярным» диагнозам сегодня принадлежит уреаплазмоз. В настоящее время этот термин признан некорректным, и чаще всего на практике ставится диагноз «уреаплазменная инфекция».
Обнаружение уреаплазмы парвум (Ureaplasma parvum) или уреаплазмы уреалитикум (Ureaplasma urealyticum) при беременности становится поводом для лечения сильнодействующими антибиотиками, что вызывает обоснованные опасения у женщин. Так ли это необходимо и в каких случаях оправдано?
Норма или болезнь?
О том, как уреаплазма влияет на ход беременности, информации много, но вся она противоречива. Исследования продолжаются, результаты каждого следующего то дополняют, то опровергают предыдущие. Информация о последствиях в виде гибели плода, недостаточного веса и инфицирования новорожденных, кажется, не оставляет женщине выбора — нужно лечить.
При этом сама бактерия относится к условно патогенным и присутствует в нормальной микрофлоре слизистых у 70% женщин европеоидной расы в низком титре. Западные медики не считают уреаплазмоз инфекцией, отдельно её не диагностируют, не лечат. Но беременность — не время игнорировать риски, потому следует разобраться. 
При нарушении бактериального баланса, гормональных перестройках, в результате ослабления иммунитета (а все эти состояния характерны для нормальной беременности), условно патогенные микроорганизмы способны неконтролируемо размножаться. Тогда это уже не норма, а реальная угроза для здоровья.
Современная диагностика выделяет два вида, которые объединяют одним термином Ureaplasma spp:
- уреаплазма парвум — вызывает воспаление уретры, придатков матки, мочекаменную болезнь, сильно снижает местный иммунитет;
- уреаплазма уреалитикум — способна проникать внутрь здоровых клеток, прикрепляться к сперматозоидам, чем снижает их активность.
Особенностью их жизнедеятельности является расщепление мочевины. В результате получаются вещества, обжигающие слизистые оболочки, что приводит к воспалению. При наличии воспалительного процесса, уреаплазма считается болезнью, ставится диагноз — уреаплазменная инфекция.
Симптомы уреаплазменной инфекции при беременности
Признаки уреаплазмоза неспецифичны, их невозможно отличить от симптомов других мочеполовых инфекций без лабораторного обследования. В начале беременности женщины легко могут принять небольшие выделения и боли за нормальные проявления гормональной перестройки. Каждый организм индивидуален, реагирует по-своему, но есть и общие симптомы:
- выделения (от скудных до обильных) бесцветные, не имеют запаха;
- неприятное жжение сопутствует опорожнению мочевого пузыря;
- если присутствуют половые контакты, их могут сопровождать непривычные ощущения: от лёгкого дискомфорта до выраженных болей, выделений с кровью;
- при быстро прогрессирующем воспалении или заражении органов малого таза наблюдается повышение температуры до 38 °C.
Если причина заболевания только уреаплазма, то симптомов может не быть вовсе или, внезапно появившись, они проходят за несколько дней. При этом возбудитель никуда не исчезает, продолжая пребывать в организме скрыто, но при первой же возможности даст о себе знать.
Чаще бактерия усиленно размножается на фоне другой половой инфекции. В таком случае симптомы смазываются, приобретают специфику второй инфекции. Так, уреаплазма и гарднерелла вместе проявятся выделениями с характерным запахом тухлой рыбы. Гарднерелла при беременности создаёт условия для размножения уреаплазмы, эти заболевания часто диагностируют одновременно. 
- мочевой пузырь — все признаки цистита;
- мочеточники и почки — потемнение мочи со следами крови;
- шейка матки — при беременности заражение проявится влагалищными выделениями и ноющими болями;
- маточные трубы и яичники — опоясывающие боли от низа живота до поясницы.
В чём опасность уреаплазмы и стоит ли её лечить?
Выводы о безусловной связи уреаплазмы с развитием патологий при беременности делать пока рано, последствия заражения на разных сроках изучены не до конца.
Корректно сформулировать мнение официальной медицины по данной проблеме можно так: прямых подтверждений влияния именно уреаплазмы на беременность нет, но статистика отмечает большой процент выявления этого микроорганизма у женщин с патологиями беременности и отклонениями в развитии новорождённых. Нередко уреаплазма становится одной из причин бесплодия.
Перечислим патологии, часто сопровождаемые повышенным количеством уреаплазмы:
- патологическое изменение фаллопиевых труб, что приводит к их непроходимости, риску внематочной беременности, бесплодию;
- при распространении заражения на шейку матки наблюдается её «рыхлость», что может спровоцировать преждевременные роды;
- самопроизвольные выкидыши на ранних сроках, замирание беременности (регрессирующая беременность);
- известны случаи возникновения эндометрита (воспаления матки) после кесарева сечения.
Женщин больше беспокоит то, чем опасна уреаплазма парвум при беременности для ребёнка. Часто наличие уреаплазмоза во влагалище никак не отражается на развитии плода. Проблемы начинаются, когда инфекция распространяется на матку. Внутриматочная инфекция может привести к заражению плода и развитию серьезных проблем со здоровьем. Во время родов ребёнок также неминуемо получает инфекцию.
Некоторые патологии новорождённых, которые связывают с уреаплазмозом:
- При заражении плаценты замедляется развитие плода. На ранних сроках это грозит остановкой развития («замершая» беременность), на поздних — рождением недоношенного младенца. Дети рождаются с низкой массой тела.
- Во время родов прохождение по заражённым родовым путям в зависимости от органа, получившего инфекцию, может вызвать у новорождённого: воспаление лёгких, поражение глаз, мочеполовой сферы.
- В редких случаях, когда организм ребёнка сильно ослаблен, развивается менингит.
Следовательно на вопрос — опасна ли уреаплазма, однозначного ответа нет. Опасность тем выше, чем слабее организм, и для ребёнка рисков больше, чем для матери.
Диагностика и лечение
Выявлять и лечить инфекции безопаснее на этапе планирования беременности. Между окончанием лечения и зачатием должно пройти 2—3 месяца. В таком случае ни последствия уреаплазмоза, ни действие лекарств никак не скажутся на ребёнке и не навредят ему.
Обязательная диагностика на уреаплазму парвум предписана таким категориям женщин:
- после лечения инфекций, передающихся половым путём, если планируется беременность;
- при невозможности забеременеть по неустановленным причинам;
- если имелись замершие беременности, выкидыши, преждевременные роды;
- частая смена партнёров или незащищённый половой акт.
Просто обнаружить уреаплазму недостаточно для постановки диагноза, нужно обязательно выявить её количество. Только превышение определённого порога, наличие симптомов и лабораторные данные о присутствии воспаления являются показаниями для лечения. Таким порогом считается показатель уреаплазмы при беременности 10 в 4 степени КОЕ/мл.
Для лечения уреаплазменной инфекции во время беременности обычно назначают Джозамицин. Курс терапии — 10 дней. Дозировка устанавливается врачом. При наличии смешанной инфекции дополнительно могут быть назначены свечи и вагинальные таблетки с антибиотиками и противогрибковыми препаратами. Народные средства при уреаплазменной инфекции не эффективны и не защищают малыша от возможного заражения.
Лечить уреаплазму при беременности начинают не раньше, чем все органы и системы плода сформируются (во 2-м триместре). При подборе лекарств, установлении схемы и длительности лечения учитывают все осложнения и риски, ведь для лечения применяются антибиотики. Важно не только вылечить женщину, но и не навредить малышу при этом. 
- Вовремя выявленный уреаплазмоз излечивается современными методами без вреда для матери и ребёнка.
- Если принято решение о медикаментозном лечении, следует строго придерживаться назначений, не отменять препараты самовольно, проходить предписанные обследования.
- Отклонения и патологии наблюдаются в основном у женщин с пониженным иммунитетом, анемией, осложнениями и абортами в прошлом. Здоровый, крепкий организм в состоянии самостоятельно удерживать микроорганизмы в безопасном количестве.
Уреаплазма, обнаруженная во время беременности, не должна становиться причиной паники у будущей мамы. Такие результаты анализов следует обсудить с врачом, и решение принимать только с его участием.
Нужные организации на карте твоего города
Женщина – прекрасное создание. Это сказано не просто так. Каждая представительница этого пола является уникальной. Для каждой женщины в этой жизни предназначено своё место, но единственное, что можно сказать обо всех прекрасных созданиях, что каждая из них рождена, чтобы стать матерью.
Период беременности — это самое счастливое время в жизни любой женщины. То самое чувство, когда будущая мать ожидает своего малыша, не должно быть расстроено ничем, особенно какими-либо болезнями. Недуги сами по себе не совсем приятное состояние, а в период вынашивания ребёнка с ними и вовсе не хотелось бы сталкиваться. Любое болезненное состояние матери может негативно сказаться на здоровье будущего ребёнка. Поэтому специалисты настоятельно рекомендуют проходить проверку и профилактику своего организма, ещё до того, как женщина планирует беременность.
Профилактика здорового образа жизни
Поддерживать здоровое состояние своего организма можно при соблюдении обычных норм гигиены и здорового образа жизни. Ученные подтвердили тот факт, что все бактерии, возбуждающие ту или иную болезнь, находятся в организме человека. Отдельное внимание уделяется бактериям, находящимся в микрофлоре влагалища женщины. Практически 90% микроорганизмов, так называемые лактобациллы, которые проживают в организме женщины, могут вызвать болезни только в случае механического воздействия на них. То есть при простуде женщины или заболевании, передающимся половым путём.
Остальные 10% бактерий относятся к условно-патогенным бактериям. Такие микроорганизмы находятся в теле человека и не размножаются до тех пор, пока иммунитет человека остаётся сильным. Как только здоровье слабеет, патогенные бактерии начинают увеличивать своё количество, и болезнь развивается. Их размножение также может быть вызвано различными стрессовыми ситуациями, сбоем иммунитета на нервной почве.
К ряду заболеваний, вызванных условно-патогенными бактериями, относятся гарднереллез, кандидоз, бактериальный вагиноз и уреаплазма. О последней болезни (уреаплазма или уреаплазмоз) будет указано более подробное описание.
Уреаплазмоз это инфекционное заболевание, которое развивается в организме человека как женщины, так и мужчины, путём размножения условно-патогенных бактерий уреаплазмы. Уреаплазмоз это также воспалительный процесс в мочеполовой системе человека, который очень часто путается с другими воспалительными заболеваниями. Его легко перепутать, так как симптомы этого недуга практически такие же, как и у многих болезней мочеполовой системы организма человека.
Есть не один вид уреаплазмоза, но самый наиболее распространённый вид этого заболевания это уреаплазма парвум и второй – «U. urealiticum». «Уреаплазма специес» — так называют эти два вида вместе. Когда выясняется, что гинеколог обнаруживает уреаплазма парвум при беременности, следует взяться за долгое и упорное лечение. Для этого понадобится некоторые антибактериальные средства, иммуностимуляторы, средства, которые помогают восстанавливать слизистую оболочку и ткани половых органов изнутри.
Симптомы заболевания уреаплазмоз
Уреаплазмоз можно определить по следующим симптомам: у женщины начинаются белесые выделения, слизистой консистенции. Это довольно распространённые симптомы любой другой болезни в мочеполовой системе. Женщины нередко путают их с молочницей или любым другим заболеванием. Но здесь стоит брать во внимание недавно произошедший половой акт. Чаще всего уреаплазма развивается и передаётся половым путём. При неуверенности в определении болезни по симптомам, нужно немедленно обратиться к врачу-гинекологу.
Симптом выделений белого цвета по длительности недолгий. Он быстро проходит, и поэтому зачастую, женщина думает, что заболевание прошло. В этом большая ошибка многих больных. После прекращения выделений болезнь протекает дальше незаметно. Зарождается уреаплазмоз во влагалище женщины, и при не лечении недуга, он перебирается на мочевые каналы, а затем и к матке. В этом и состоит его негативное качество.
Если уреаплазма перебирается дальше по организму и переходит на матку, женщина имеет риск стать бесплодной. Если болезнь начинает двигаться вверх по организму, у женщины начинают проявляться новые симптомы. Начинает болеть низ живота так, как будто что-то тянет вниз. В таких случаях уреаплазма путается с циститом. Также болезнь может распространиться на почки. Если будет задета слизистая оболочка почек, нарушатся их функция, и это приведёт к осложнениям в мочевой системе женщины. Данная болезнь очень нежелательна, особенно если дама беременная.
Уреаплазмоз при беременности
Если будущая мать заболела этим недугом ещё до зачатия, то его лучше вылечить, не будучи беременной. Угроза заболевания ребёнка уреаплазмозом достаточно высока. В этом состоянии уреаплазма при беременности легко передать недуг ещё не родившемуся ребёнку. Пока идёт период вынашивания, болезнь опасна, так как инфекция находится и в крови, и в слизистой оболочке стен влагалища. Но ребёнок может заразиться во время прохождения им родовых путей матери и стать больным. Уреаплазма у женщин причины возникновения при беременности бывают разными, но в основном из-за неудачного полового акта.
Ребёнок, который заразился во время рождения, может иметь в своём организме уже заражённые клетки . Но эти клетки будут в спящем состоянии, не будут действовать долгое время. Такая болезнь может остаться хронической. Практически любая болезнь, не только данная уреаплазма у женщины при беременности должна быть вылечена задолго до того, как женщина собирается дать жизнь новому человеку.
Если же беременной женщине не удалось вылечить свою болезнь до момента зачатия, если не удалось ей и во время беременности от неё избавиться, и случилось так, что ребёнок родился, его сразу следует отправить на осмотр к врачу. Сделать это следует довольно быстро, уреаплазма при беременности последствия для ребёнка могут быть плачевными и малыша нужно сразу лечить. Если болезнь останется не вылеченной, и перейдёт в хроническое заболевание, у него могут развиться те же болезни, что и при запущенном состоянии уреаплазмоза. То есть это проблемы с почками, мочевыми каналами и угроза бесплодия.
Угроза уреаплазмоза при беременности
При беременности присутствие этого заболевания выделить ещё сложнее. В случае симптомов, то они часто встречаются практически у любой женщины, находящейся в интересном положении. Особенно если это тянущие боли в нижней части живота. При таком положении, проходить консультацию врача-гинеколога рекомендуется достаточно часто. А при обнаружении заболевания, вести немедленное лечение.
Если женщина беременная, любая болезнь не будет оказывать ни на неё, ни на её будущего ребёнка, никакого положительного действия, я думаю это понятно. При запускании болезни и не лечении уреаплазмы, последствия окажутся серьёзными. Заражённые и невылеченные участки половой системы организма женщины скажутся на её репродуктивной функции. Переход болезни на мочевой пузырь или почки также влияет на эти прямые функции.
Если беременная женщина страдает уреаплазмозом, то в её организме развивается такая микрофлора, что она является благоприятной для множества других болезней. Так, уреаплазма и гарднерелла при беременности хорошо развиваются вместе. Практически все эти болезни являются заболеваниями, передающимися половым путём. В случае когда женщина имеет количество бактерий уреаплазмы в организме, не превышающих нормы, её называют носителем. При таком обстоятельстве, сама она не болеет, но заражает своих половых партнёров. Даже при таком положении дел, ей всё равно надо лечиться, так как любой стресс в организме или нервная ситуация, могут дать толчок развитию болезни.
При беременности женщины больной ураплазмозом, могут быть негативные последствия как для неё самой, так и для ребёнка. Если срок беременности ещё не превысил первого триместра, а болезнь уже перешла на область матки или шейки матки, есть опасения выкидыша и большой кровопотери. В этом случае не все врачи пришли к единому мнению – можно ли лечить это заболевание на раннем сроке, что лучше выбрать? Как известно, уреаплазма лечится антибиотическими средствами и препаратами. Если беременность не превышает двенадцати недель, приём антибиотиков очень негативно скажется на здоровье плода. Здесь выбор стоит только за самой женщиной.
Если же, наоборот, срок уже довольно большой, но до рождения ребёнка ещё рано, могут произойти преждевременные роды, так как тянущие боли в нижней области живота могут вызвать частое сокращение матки, что приведёт к раскрытию её шейки, и начнутся родовые схватки. Тогда при рождении ребёнок уже может глотать ртом воздух, и инфекция проникает через дыхательные пути. На этот счёт многие специалисты также ведут неоднозначные споры.
Диагностика уреаплазмы при беременности
Если женщина, будучи беременной, болеет уреаплазмозом, то начать лечение может только с 22 недели. Такое ограничение было принято для того, чтобы лечение, проходящее при помощи антибиотиков никак не повлияло на состояние плода и его здоровье.
Определить эту болезнь по симптомам не всегда бывает легко, а диагностировать её на приёме у врача не всегда получается с первого раза. Как было сказано выше, женщина может являться всего лишь носителем инфекции. В таких случаях состояние микрофлоры половых органов женщины, на первый взгляд, ничем не отличается от органов здорового человека. Если же врач сомневается в показателях осмотра и сама пациентка жалуется и определяет какие-либо симптомы, необходимо сдать определённые анализы. Если случай является таким, что женщина действительно является носителем уреаплазмоза, это ещё не говорит о том, что она им болеет. Для точного выявления болезни каждая женщина может пройти диагностику на эту болезнь.
На данный момент в медицинской практике есть всего три способа диагностики заболевания, которые могут с точностью определить наличие этого недуга у человека.
- ПЦР (полимерная цепная реакция), она позволяет выявить ДНК того, кто возбудил или передал эту болезнь. Проводится эта процедура путём сдачи анализов на мазок из влагалища женщины или шейки матки, также у мужчин может браться мазок из уретры. Во многих медицинских учреждениях этот анализ проводится довольно быстро. Требуется практически пару часов для подтверждения наличия заболевания. Но данный вид диагностики не может помочь определить количество вещества, то есть количество уреаплазмы, её микроорганизмов. Следовательно, нельзя понять болеет ли человек или является носителем. Также нельзя будет понять при болезни, развивается ли она или идёт процесс улучшения.
- Серологический метод. Если произошёл выкидыш или преждевременные роды, то по согласию роженицы, если есть подозрения на эту болезнь, берут анализы на антигены и антитела к ним. В этом случае берётся кровь из вены. По этому параметру уже можно будет выяснить точное число бактерий и степень осложнения болезни.
- Бактериологический посев. Данный метод используется чаще остальных, так как результаты его могут ответить на большинство вопросов. Для этой процедуры также берутся мазки из влагалища женщины и мазок у мужчины из уретры. Но мазки непросто проверяются под микроскопом на наличие бактерий. Мазок помещается в специальную среду, имитирующую микрофлору организма больного, то есть, как будто они находятся в организме, из которого были взяты. В большинстве случаев это просто моча того же человека. По результатам этого исследования определяют точное количество микроорганизмов, наличие других бактерий. Если анализы были сданы беременной женщиной, то по этой процедуре можно точно назначить лечение и антибиотики, по которым она будет лечиться.
Любую болезнь нужно быстро и именно правильно диагностировать, потому что иначе можно лечить что-то не то. В итоге это усугубит ситуацию, что будет критично как для малыша, так и матери.
